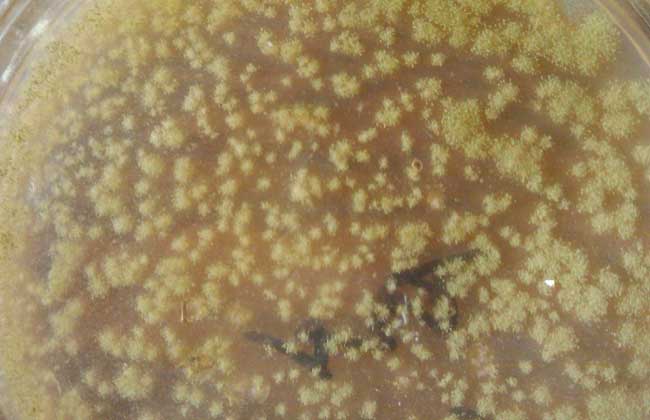
放线菌属于细菌吗？
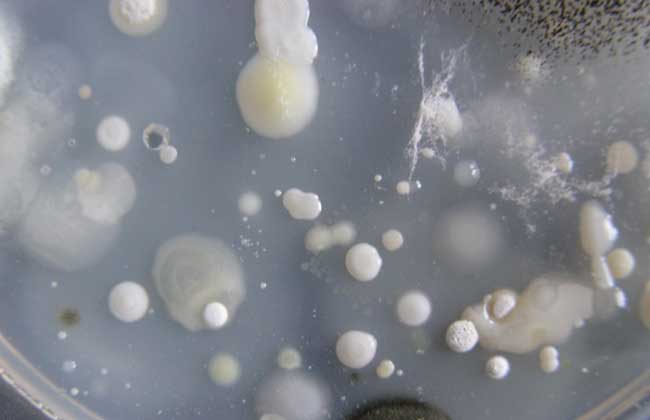
放线菌属于细菌吗？

放线菌是一类主要呈菌丝状生长和以孢子繁殖的陆生性较强大的原核生物,因在固体培养基上呈辐射状生长而得名,在自然界中分布很广,主要以无性孢子的方式,可产生抗生素等,用于污水处理等,下面我们就一起来看一看放线菌是不是细菌吧!

放线菌属于细菌吗?
放线菌是细菌,与一般细菌一样,多为腐生,少数寄生。与人类的生产和生活关系极为密切,广泛应用的抗生素约70%是各种放线菌所产生,一些种类的放线菌还能产生各种酶制剂、维生素和有机酸等。此外,放线菌还可用于甾体转化、烃类发酵、石油脱蜡和污水处理等方面。少数放线菌也会对人类构成危害,引起人和动植物病害。因此,放线菌与人类关系密切,在医药工业上有重要意义。
放线菌的结构特征
放线菌细胞的结构与细菌相似,都具备细胞壁、细胞膜、细胞质、拟核等基本结构。个别种类的放线菌也具有细菌鞭毛样的丝状体,但一般不形成荚膜、菌毛等特殊结构。放线菌的孢子在某些方面与细菌的芽孢有相似之处,都属于内源性孢子,但细菌的芽孢仅是休眠体,不具有繁殖作用,而放线菌产生孢子则是一种繁殖方式。
放线菌的代表种属
1、链霉菌属:链霉菌属共约1000多种,其中包括和很多不同的种别和变种,具有发育良好的菌丝体,菌丝体分枝,无隔膜,直径约0.4~1微米,长短不一,多核。菌丝体有营养菌丝、气生菌丝和孢子丝之分,孢子丝再形成分生孢子。
2、诺卡氏菌属:诺卡氏菌属又名原放线菌属,这个属的特点是在培养15小时至4天内,菌丝体产生横隔膜,分枝的菌丝体突然全部断裂成长短近于一致的杆状或球状体或带杈的杆状体。每个杆状体内至少有一个核,因此可以复制并形成新的多核的菌丝体。
3、放线菌属:放线菌属多为致病菌,只有营养菌丝,直径小于1微米,有横隔,可断裂成“V”形或“Y”形体。无气生菌丝,也不形成孢。一般为厌气菌或兼性厌气菌。引起牛颚肿病的牛型放线菌是此属的典型代表。另一类是衣氏放线菌,寄生于人体,可引起后颚骨肿瘤和肺部感染。
4、小单孢菌属:小单孢菌属菌丝体纤细,直径0.3~0.6微米,无横隔膜、不断裂、菌丝体侵入培养基内,不形成气生菌丝。只在菌丝上长出很多分枝小梗,顶端着生一个孢子。
5、链孢囊菌属:链孢囊菌属主要特点是能形成孢囊和孢囊孢子,有时还可形成螺旋孢子丝,成熟后分裂为分生孢子。此属菌的营养菌体分枝很多,横隔稀少,直径0.5~1.2微米,气生菌丝体成丛、散生或同心环排列。此属菌约15种以上,其中因不少种可产生广谱抗生素而受到重视。
6、游动放线菌属:游动放线菌属通常在沉没水中的叶片上生长,气生菌丝体一般有或极少,营养菌丝分枝或多或少,隔膜或有或无,直径约0.2~2.6微米,以孢囊孢子繁殖。孢囊形成于营养菌丝体上或孢囊梗上,孢囊梗直形或分枝,每分枝顶端形成一至数个孢囊,孢囊孢子通常略有棱角,并有一至数个发亮小体或几根端生鞭毛,能运动是此属菌最特殊之处。